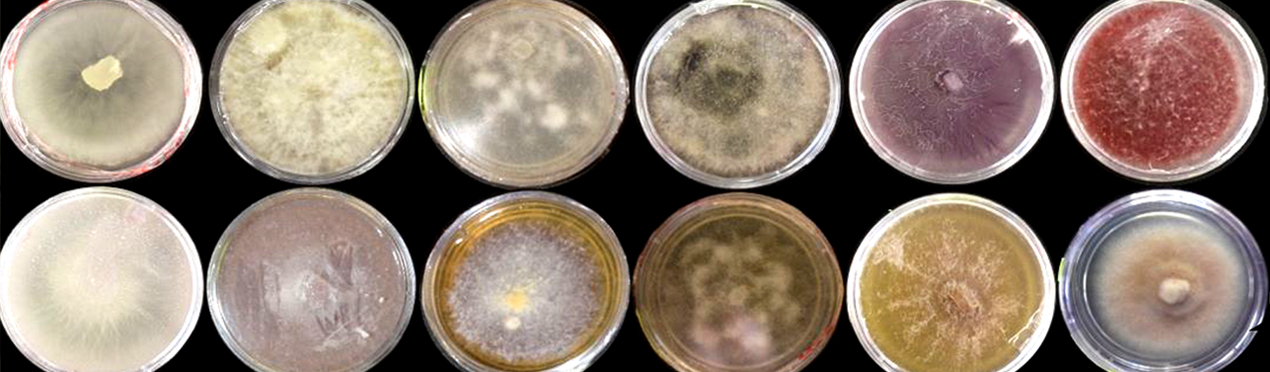

Los diminutos escarabajos del musgo
Roberto Arce-Pérez y Daniel Reynosos-Velasco
Red de Biodiversidad y Sistemática

Los diminutos escarabajos del musgo forman una familia de coleópteros acuáticos denominados Hydraenidae. Presentan gran capacidad adaptativa y amplia distribución. En México se registran 71especies, siendo 36 exclusivas del país.